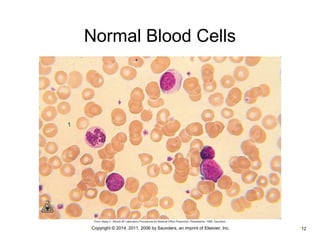
Normal Blood Cells 
•Copyright © 2014, 2011, 2006 by Saunders, an imprint of Elsevier, Inc. •12
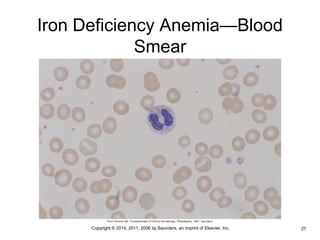
Iron Deficiency Anemia—Blood 
Smear 
•Copyright © 2014, 2011, 2006 by Saunders, an imprint of Elsevier, Inc. •27
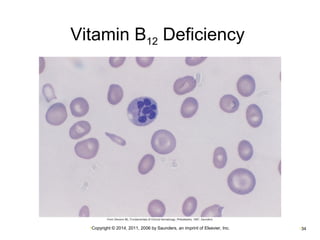
Vitamin B12 Deficiency 
•Copyright © 2014, 2011, 2006 by Saunders, an imprint of Elsevier, Inc. •34
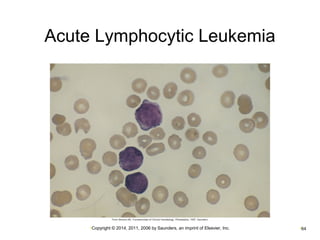
Acute Lymphocytic Leukemia 
•Copyright © 2014, 2011, 2006 by Saunders, an imprint of Elsevier, Inc. •64
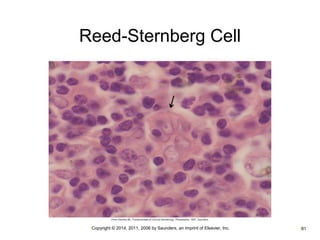
Reed-Sternberg Cell 
•Copyright © 2014, 2011, 2006 by Saunders, an imprint of Elsevier, Inc. •81

This document provides an overview of blood and circulatory system disorders. It begins with a review of the circulatory system and its components. It then discusses blood vessels including arteries, veins, and capillaries. Next, it covers the components and functions of blood, including plasma, red blood cells, white blood cells, and platelets. The document proceeds to describe various blood disorders such as anemias, hemolytic anemia, sickle cell anemia, and aplastic anemia. It provides details on diagnostic tests and blood therapies for treating various blood-related conditions.

![Control of the Heart
Cardiac control center in medulla oblongata
Controls rate and force of contraction
Located in the medulla
Baroreceptors
Detect changes in blood pressure
Located in the aorta and internal carotid arteries
Sympathetic stimulation (cardiac accelerator nerve)
Increases heart rate (tachycardia)
Parasympathetic stimulation (cranial nerve [CN] X;
vagus nerve)
Decreases heart rate (bradycardia)
•Copyright © 2014, 2011, 2006 by Saunders, an imprint of Elsevier, Inc. •99](https://image.slidesharecdn.com/chapters10-12-141005182827-conversion-gate01/85/Ch-10-11-12-Pathology-99-320.jpg)








































































































